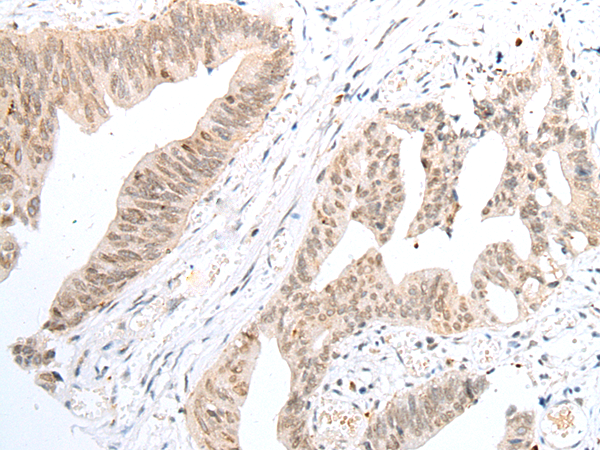

提醒成功

搜索
Rabbit Polyclonal Antibody to NUDT6
-
货号:
P02142 -
别名:
GFG1; GFG-1; ASFGF2; FGF-AS; FGF2AS -
应用:
IHC -
反应种属:
Human, Mouse, Rat -
抗体类型:
Primary antibody -
Swissprot:
P53370 -
规格:
-
数量:
-+ -
说明书:
目录价¥1980

Rabbit Polyclonal Antibody to NUDT6
Description |
|---|
This gene overlaps and lies on the opposite strand from FGF2 gene, and is thought to be the FGF2 antisense gene. The two genes are independently transcribed, and their expression shows an inverse relationship, suggesting that this antisense transcript may regulate FGF2 expression. This gene has also been shown to have hormone-regulatory and antiproliferative actions in the pituitary that are independent of FGF2 expression. Alternatively spliced transcript variants encoding different isoforms have been found for this gene. |
Specification |
|
|---|---|
| Aliases | GFG1; GFG-1; ASFGF2; FGF-AS; FGF2AS |
| Swissprot | P53370 |
| Host/Isotype | Rabbit IgG |
| Antibody Type | Primary antibody |
| Storage | Store at 4°C short term. Aliquot and store at -20°C long term. Avoid freeze/thaw cycles. |
| Species Reactivity | Human, Mouse, Rat |
| Immunogen | Fusion protein of human NUDT6 |
| Formulation | Purified antibody in PBS with 0.05% sodium azide and 50% glycerol. |
Application |
|
|---|---|
| IHC | 1/25-1/100 |
| ELISA | 1/5000-1/10000 |
Product Image
- The image is immunohistochemistry of paraffin-embedded Human thyroid cancer tissue using P02142(NUDT6 Antibody) at dilution 1/30. (Original magnification: ×200)
- The image is immunohistochemistry of paraffin-embedded Human colorectal cancer tissue using P02142(NUDT6 Antibody) at dilution 1/30. (Original magnification: ×200)
For Reseach Only
Application Key:WB - Western Blot | IHC - Immunohistochemistry | ICC - Immunocytochemistry | FCM - Flow Cytometry | ELISA - Enzyme-linked Immunosorbent Assay | IP - Immunoprecipitation
#P02142

相关产品















 微信/QQ登录
微信/QQ登录


 首页
首页